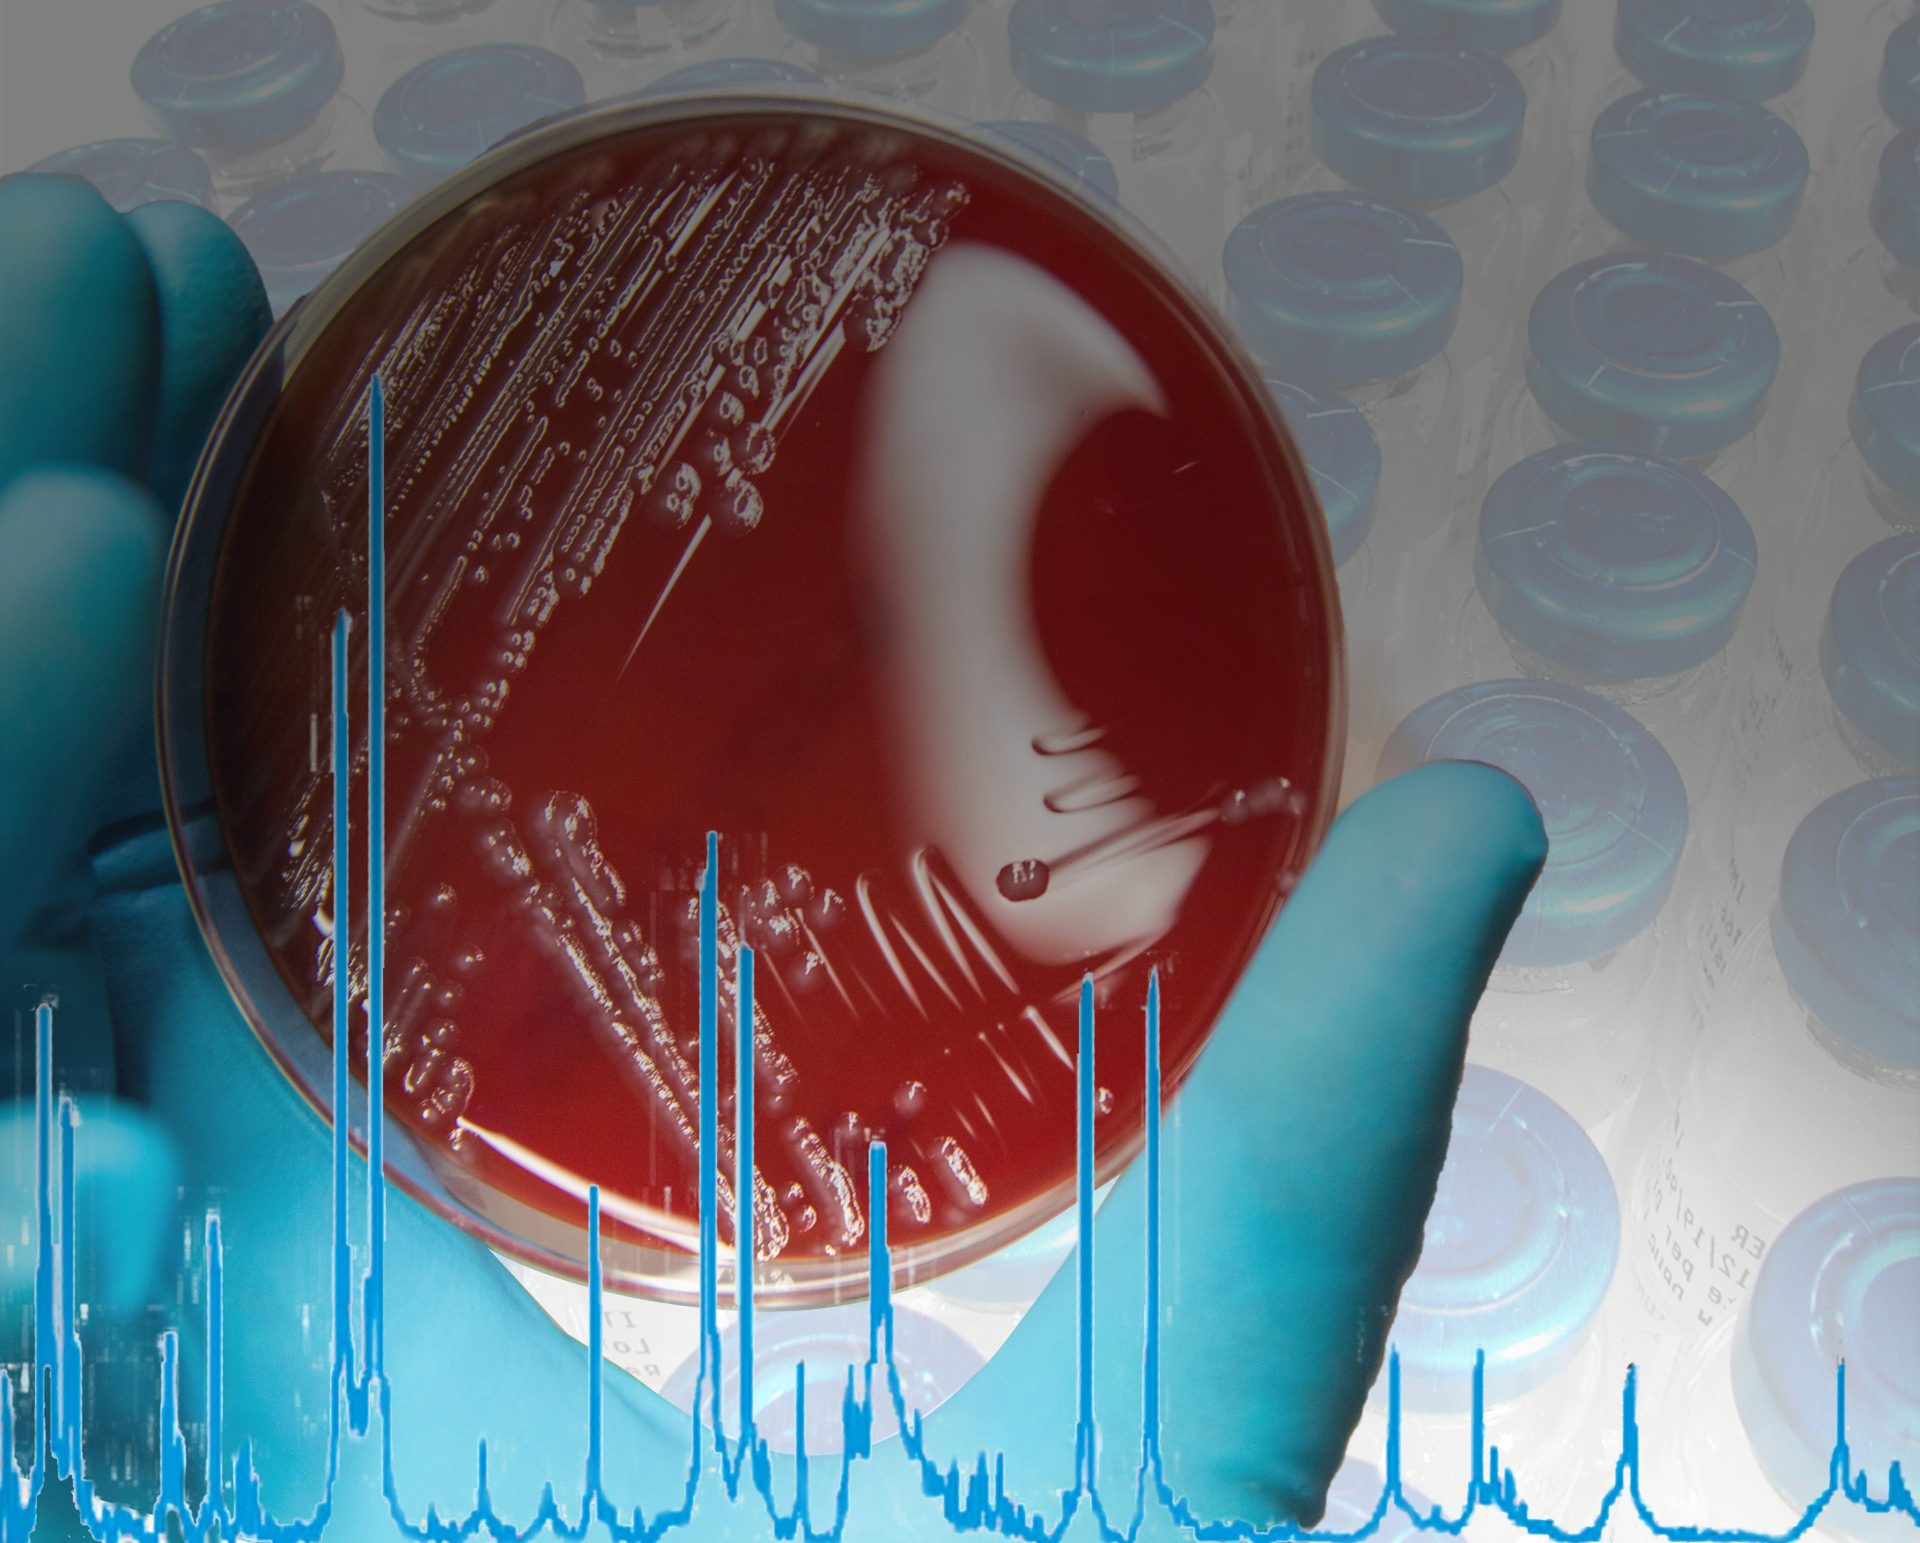

MALDI Biotyper® for Pharma
Straightforward to result
The MALDI Biotyper® (MBT) is a rapid microbiological method for identification based on the unique proteomic fingerprint of a microorganism. Proteomic patterns of unknown microorganisms, acquired by Matrix-Assisted Laser Desorption/Ionization Time-Of-Flight Mass Spectrometry (MALDI-TOF MS), are compared to an extensive, ready-to-use reference library that covers thousands of species.
Even demanding microorganisms like anaerobic and non-fermenting bacteria, as well as multicellular fungi, can be identified with one approach. No expertise in mass spectrometry is required and the identification can be obtained in-house within minutes. Implementing the MALDI Biotyper® in the QC workflow can translate to high cost savings in terms of saving lost product shipments and production line uptime.
Broad species coverage
The MBT Compass reference library version 2023 covers 4,320 species from 712 microorganism genera. The library is continuously maintained and updated according to strict quality-controlled procedures. Additionally, specific libraries for filamentous fungi and mycobacteria are also available. Laboratories have as well the option to create their own reference libraries from their spectra, for example on specific local microorganisms. These custom libraries can be shared and exchanged with other plants of the pharmaceutical company and externally.
Process control
Already in use in a number of pharmaceutical microbiology labs, the MALDI Biotyper® provides a very rapid and specific microbial identification result, comparable to molecular sequencing resolution, but with significantly less labor, time and cost. The implementation and validation of the MALDI Biotyper® is supported by installation qualification (IQ) and operational qualification-performance validation (OQ-PV) documentation and 21 CFR Part 11 supporting software. For daily routine documentation requirements, the MALDI Biotyper® solution offers complete workflow traceability.
More Information
-
MALDI Biotyper® for Pharma (Brochure), GP
(PDF, 3 MB)
-
Faster identification method for pharmaceutical microbiology with the MALDI Biotyper® (Application Note)
(PDF, 339 KB)
-
The MALDI Biotyper® enables increased throughput and reliability in pharmaceutical microbial testing, GP (Expert insight)
(PDF, 1 MB)
-
ACT Ecolabel (Flyer)
(PDF, 1 MB)
-
Rapid microbial identification in pharmaceutical laboratories (Article)
(PDF, 242 KB)
-
MALDI Biotyper® for biopharmaceuticals productions using yeast strains (Article)
(PDF, 147 KB)
-
Key microbes identified in pharmaceutical routine monitoring (Article)
(PDF, 624 KB)
-
Efficient Burkholderia cepacia complex identification in pharmaceuticals (Article)
(PDF, 622 KB)
-
Fungal identification in pharmaceutical laboratories (Article)
(PDF, 792 KB)


